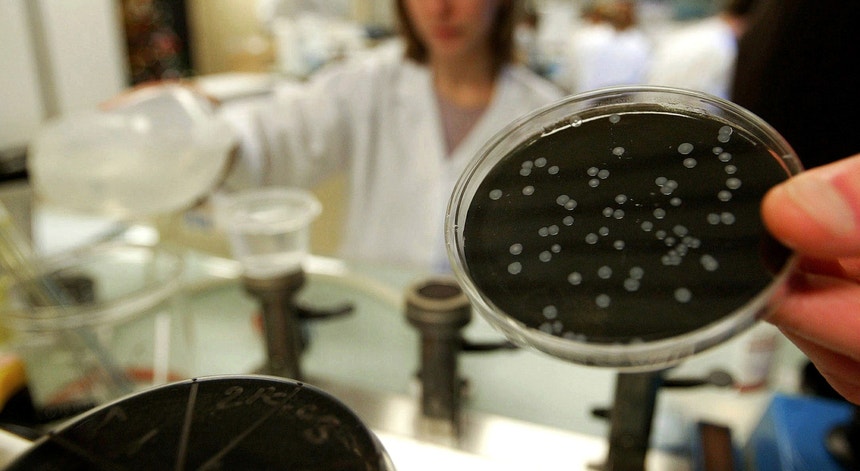

País
Programa de vigilância da legionella nos hospitais arranca este mês
O programa de vigilância e prevenção sanitária da legionella nos hospitais portugueses, coordenado pelo Instituto Nacional de Saúde Ricardo Jorge, arranca este mês. Fernando Almeida, presidente da instituição, afirmou à Antena 1 que o programa não tem como objetivo fiscalizar os hospitais e sancionar quem não cumpre as regras. E, sem concretizar, diz que já foram identificados alguns hospitais com maior risco.
“Este programa não vai ser de fiscalização, nem vai ser um programa efetivamente virado para atos de fiscalização, vai ser apenas de vigilância”, afirmou Fernando Almeida.
Segundo o responsável pelo Instituto Nacional de Saúde Ricardo Jorge, “todo este programa exige uma calendarização e articulações com as entidades de saúde”.
Sem avançar com casos concretos, o presidente do Instituto Ricardo Jorge aponta que, numa fase inicial, foram identificados alguns hospitais com maior risco de não cumprirem com as normas de prevenção.
O objetivo é “identificar a partir de uma listagem de uma avaliação que foi feita em plena crise da legionella do São Francisco Xavier, (...) quais eram os hospitais, segundo a avaliação de risco, que seriam prioritários”.
Entrevista de João Torgal - Antena1
Fernando Almeida explicou que “quando entra num hospital não pode ir fazer colheitas de água para fazer análises da legionella, sem um critério definido”.
“Há determinados pontos críticos, sejam as torres de arrefecimento, os condensadores, chuveiros. Uma série de pontos que nós teremos de identificar”.
É necessário, nos vários tipos de hospitais, identificar “quais é que devem inspirar uma maior atenção”.
Objetivo é prevenir
Fernando Almeida nega que o programa tenha objetivos de fiscalização e de sancionar que não cumpre com as normas.
“Há responsabilidades das próprias empresas, das próprias administrações dos hospitais, dos centros de saúde que têm a ver, essas sim, com a monotorização e com o controlo. Se eu tenho uma empresa que fornece um determinado serviço, eu tenho de ser responsável pelo produto que estou a oferecer e isso passa por um processo de educação e de chamada de atenção”, acrescentou.
O responsável da instituição garante que está “convencido que todos os hospitais fazem um esforço muito grande em relação a esta matéria. E estão a fazer um esforço muito grande em relação ao cuidado que têm e à vigilância que têm em relação à monotorização das suas infraestruturas tendo em vista prevenir que aconteçam mais casos”.
Fernando Almeida esclareceu que o objetivo principal do programa é “prevenir que as coisas possam acontecer, ou possam ocorrer e colaborar com as autoridades gestoras para que tudo seja reposto se não estiver em condições”. Prevenção avança nos hospitais públicos
Os hospitais públicos serão os primeiros a ser analisados. “Nós temos de começar por algum sítio. Temos de ter um critério”.
No entanto, não quer dizer que num próximo mês, ou daqui a dois meses, “não se possa começar a trabalhar com os privados. A ideia principal foi primeiro as instituições do Ministério da Saúde”.
Fernando Almeida compreende a posição do Bloco de Esquerda que quer inspeções periódicas a todas as instalações hospitalares (públicas e privadas).
“Os hospitais são todos iguais. Os riscos são todos iguais e ainda bem que assim é. Mas o critério é fazermos primeiro nesta fase as entidades públicas e logo que houver disponibilidade e que for entendido em termos de pertinência, avançar para a parte privada”.
A Doença dos Legionários é recente
O responsável garante também que os hospitais não são uma fonte particular de perigo.
“Houve esta infeliz coincidência de haver dois fenómenos com curto intervalo no espaço de tempo, em duas unidades hospitalares. O que não quer dizer que a partir de agora todos os hospitais são um grande perigo”, afirmou Fernando Almeida.“Não é por ser um hospital que existe o risco acrescido de legionella”.
O presidente da instituição recorda o caso de Vila Franca de Xira em que “não era claramente um hospital”.
“Não é por haver dois casos que nós podemos ou vamos dizer que os hospitais são uma fonte perigosa de infeção”, frisou.
Fernando Almeida recordou que a “legionella, ou doença dos Legionários, é uma doença muito recente, data de 1976, conhece-se ainda muito pouco sobre o funcionamento desta bactéria. A única coisa que se sabe é que é ubiquitária na água”.
Profissionais mais sensibilizados
Nos últimos seis anos Portugal registou 67 óbitos provocados pela legionella. Na Alemanha foram registados 285 casos e em França 915. “Isto é um fenómeno global e que acontece em tudo”.
“Em muitos casos não é possível descobrir uma fonte comum de infeção”, frisou.
Fernando Almeida recorda que a Doença dos Legionários afeta, principalmente, as “pessoas imunodeprimidas, idosos, patologias associadas. São pessoas relativamente mais frágeis e mais suscetíveis. Porque noutros casos, mesmo sendo infetado com a legionella, não desenvolvem o quadro de pneumonia e aqui é que é a gravidade do quadro”.
Para o responsável, “com a evidência dos casos de Vila Franca e de São Francisco Xavier, o corpo clínico e todos os profissionais de saúde estão muito mais sensibilizados para a doença”.
“É natural que aconteça uma maior evidência de números em relação à legionella”, rematou.
Segundo o responsável pelo Instituto Nacional de Saúde Ricardo Jorge, “todo este programa exige uma calendarização e articulações com as entidades de saúde”.
Sem avançar com casos concretos, o presidente do Instituto Ricardo Jorge aponta que, numa fase inicial, foram identificados alguns hospitais com maior risco de não cumprirem com as normas de prevenção.
O objetivo é “identificar a partir de uma listagem de uma avaliação que foi feita em plena crise da legionella do São Francisco Xavier, (...) quais eram os hospitais, segundo a avaliação de risco, que seriam prioritários”.
Entrevista de João Torgal - Antena1
Fernando Almeida explicou que “quando entra num hospital não pode ir fazer colheitas de água para fazer análises da legionella, sem um critério definido”.
“Há determinados pontos críticos, sejam as torres de arrefecimento, os condensadores, chuveiros. Uma série de pontos que nós teremos de identificar”.
É necessário, nos vários tipos de hospitais, identificar “quais é que devem inspirar uma maior atenção”.
Objetivo é prevenir
Fernando Almeida nega que o programa tenha objetivos de fiscalização e de sancionar que não cumpre com as normas.
“Há responsabilidades das próprias empresas, das próprias administrações dos hospitais, dos centros de saúde que têm a ver, essas sim, com a monotorização e com o controlo. Se eu tenho uma empresa que fornece um determinado serviço, eu tenho de ser responsável pelo produto que estou a oferecer e isso passa por um processo de educação e de chamada de atenção”, acrescentou.
O responsável da instituição garante que está “convencido que todos os hospitais fazem um esforço muito grande em relação a esta matéria. E estão a fazer um esforço muito grande em relação ao cuidado que têm e à vigilância que têm em relação à monotorização das suas infraestruturas tendo em vista prevenir que aconteçam mais casos”.
Fernando Almeida esclareceu que o objetivo principal do programa é “prevenir que as coisas possam acontecer, ou possam ocorrer e colaborar com as autoridades gestoras para que tudo seja reposto se não estiver em condições”. Prevenção avança nos hospitais públicos
Os hospitais públicos serão os primeiros a ser analisados. “Nós temos de começar por algum sítio. Temos de ter um critério”.
No entanto, não quer dizer que num próximo mês, ou daqui a dois meses, “não se possa começar a trabalhar com os privados. A ideia principal foi primeiro as instituições do Ministério da Saúde”.
Fernando Almeida compreende a posição do Bloco de Esquerda que quer inspeções periódicas a todas as instalações hospitalares (públicas e privadas).
“Os hospitais são todos iguais. Os riscos são todos iguais e ainda bem que assim é. Mas o critério é fazermos primeiro nesta fase as entidades públicas e logo que houver disponibilidade e que for entendido em termos de pertinência, avançar para a parte privada”.
A Doença dos Legionários é recente
O responsável garante também que os hospitais não são uma fonte particular de perigo.
“Houve esta infeliz coincidência de haver dois fenómenos com curto intervalo no espaço de tempo, em duas unidades hospitalares. O que não quer dizer que a partir de agora todos os hospitais são um grande perigo”, afirmou Fernando Almeida.“Não é por ser um hospital que existe o risco acrescido de legionella”.
O presidente da instituição recorda o caso de Vila Franca de Xira em que “não era claramente um hospital”.
“Não é por haver dois casos que nós podemos ou vamos dizer que os hospitais são uma fonte perigosa de infeção”, frisou.
Fernando Almeida recordou que a “legionella, ou doença dos Legionários, é uma doença muito recente, data de 1976, conhece-se ainda muito pouco sobre o funcionamento desta bactéria. A única coisa que se sabe é que é ubiquitária na água”.
Profissionais mais sensibilizados
Nos últimos seis anos Portugal registou 67 óbitos provocados pela legionella. Na Alemanha foram registados 285 casos e em França 915. “Isto é um fenómeno global e que acontece em tudo”.
“Em muitos casos não é possível descobrir uma fonte comum de infeção”, frisou.
Fernando Almeida recorda que a Doença dos Legionários afeta, principalmente, as “pessoas imunodeprimidas, idosos, patologias associadas. São pessoas relativamente mais frágeis e mais suscetíveis. Porque noutros casos, mesmo sendo infetado com a legionella, não desenvolvem o quadro de pneumonia e aqui é que é a gravidade do quadro”.
Para o responsável, “com a evidência dos casos de Vila Franca e de São Francisco Xavier, o corpo clínico e todos os profissionais de saúde estão muito mais sensibilizados para a doença”.
“É natural que aconteça uma maior evidência de números em relação à legionella”, rematou.

